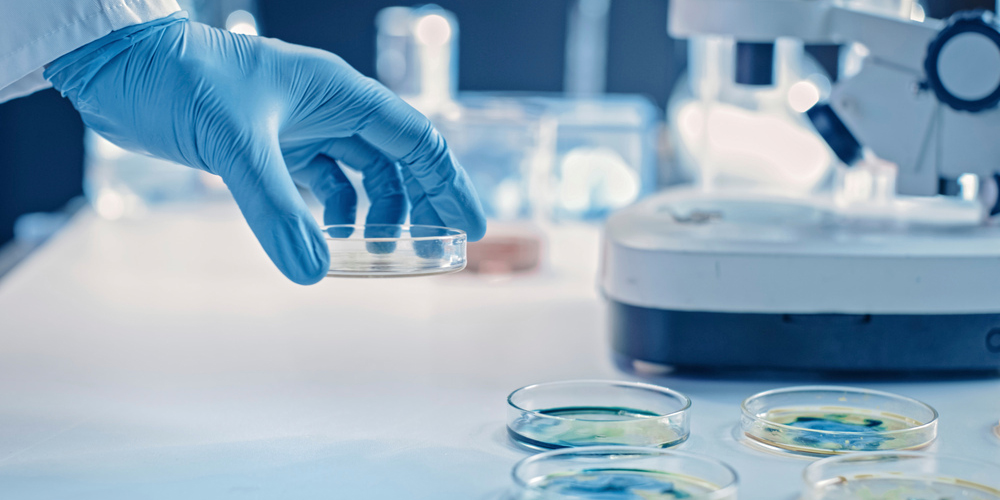

Vision & Mission
지구를 위한 방향
-
생물다양성의 과학적 이해
생물다양성에 대한 과학적 이해와 사회적 인식을 넓히는 교육 컨텐츠를 개발합니다.

-
지역 맞춤형 교육
지역생태계와 문화적 맥락을 반영한 맞춤형 교육 프로그램을 운영합니다.

-
협력 커뮤니티
전문가와 시민이 함께 참여할 수 있는 지속 가능한 학습 커뮤니티를 구축합니다.

-
기후 위기 대응 역량
교육을 통해 기후위기 대응 역량을 강화하고 생물다양성 보전 행동 실천을 유도합니다.

-
AI 기반 솔루션 제공
AI 기반 생태 솔루션으로 도시와 사회의 생물다양성 회복을 이끌어가겠습니다.

핵심가치
-
생물다양성 존중
모든 생명은 존중받아야 하며, 생태계의 균형은 사회 지속가능성의 근간입니다.
-
교육 중심성
정보 전달을 넘어서, 학습자가 실천할 수 있는 능력을 키우는 교육을 지향합니다.
-
포용성과 참여
다양한 분야의 전문가, 커뮤니티 구성원과 협력하며 지식을 공유합니다.
-
지역성 기반 접근
지역의 생태·문화적 맥락에 맞는 해법을 중시합니다.
History
지구를 위한 발자취
Business
지구를 위한 실천
다이버시티랩은 다양한 분야에서 전문성을 발휘합니다.
-
생물다양성 교육
- 환경종사자 대상 생물다양성 역량강화 교육
- 초중고 학생 맞춤형 생태교육 프로그램
- 성인 대상 생물다양성 보전 워크숍
- 교육자 양성 및 교육 콘텐츠 개발

-
환경영향평가사업
- 개발 사업 환경영향평가 수행
- 환경 측정 오염물질 데이터 분석
- 생태계 영향 시뮬레이션 연구
- 환경영향 저감 방안 수립 및 컨설팅

-
AI 기반 생물다양성 연구
- 생물종 인식 AI 모델 개발
- 생태계 변화 예측 시스템 구축
- 생물다양성 데이터베이스 설계
- 세포주와 오가노이드 분석 연구
-
환경교육 콘텐츠 개발 및 컨설팅
- 생태환경 교육 디지털 플랫폼 개발 및 운영
- 참여형 생물다양성 교육캠페인 진행
- 학교 교육과정 연계 콘텐츠 및 교구 개발
- 교육전문 인력 양성 및 컨설팅

Education Programs
지구를 위한 배움
-
 초/중/고등 교육
초/중/고등 교육학생 대상 맞춤형 교육 콘텐츠
- 학년별 맞춤형 생태교육 커리큘럼
- 체험형 생물다양성 학습 활동
- 디지털 교구재와 연계한 통합교육
- 교사용 환경교육 리소스 제공
-
 성인 및 전문가 과정
성인 및 전문가 과정AI 및 데이터 활용 학습 프로그램
- 생태데이터 수집 및 분석 워크숍
- 환경 AI 모델링 전문가 과정
- 생물다양성 정책 전문가 양성
- 환경영향평가 실무 교육
-
 시민 참여 프로그램
시민 참여 프로그램생태 투어, DIY 생태 키트
- 가족 참여형 생태탐방 프로그램
- 시민과학자 양성 워크숍
- 계절별 생태관찰 활동
- 도시 생물다양성 탐사
organization
지구를 위한 협력
-
대표이사CEO
-
경영지본부Management Support
- 인사/총무팀
- 재무/회계팀
- 기획전략팀
-
기술연구소R&D Center
- AI개발팀
- 생태데이터분석팀
- 플랫폼개발팀
- 생물다양성연구팀
-
사업본부Business Division
- 교육사업팀
- 환경컨설팅팀
- 제안/영업팀
- 홍보/마케팅팀
-
위원회 조직
- 윤리경영위원회
- ESG위원회
- 교육과정개발위원회
-
경영지본부Management Support
-
수평적 의사소통
팀 간 유기적 협업과 창의적 아이디어 교류를 위한 수평적 소통 구조를 지향합니다.
-
전문성 강화
각 분야 전문가들의 역량을 최대화하고 지속적인 학습과 연구를 지원합니다.
-
유연한 조직 문화
변화하는 환경에 신속하게 대응하기 위한 유연한 조직 구조와 업무 방식을 추구합니다.
-
다양성 존중
다양한 배경과 관점을 가진 구성원들의 협업을 통해 창의적인 솔루션을 개발합니다.
생물다양성 보전과 환경 문제 해결을 위한혁신적인 솔루션을 제공합니다.
